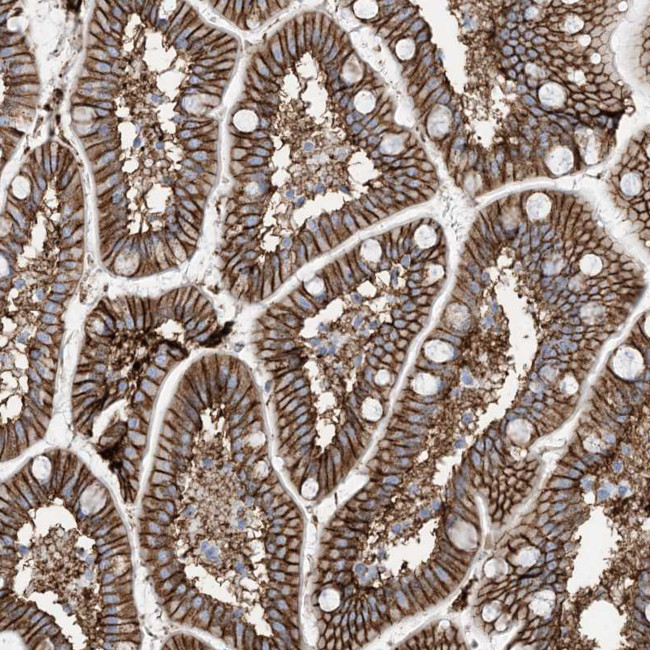
ATP11C Antibody in Immunohistochemistry (Paraffin) (IHC (P))

Search
Invitrogen
ATP11C Polyclonal Antibody
{{$productOrderCtrl.translations['antibody.pdp.commerceCard.promotion.promotions']}}
{{$productOrderCtrl.translations['antibody.pdp.commerceCard.promotion.viewpromo']}}
{{$productOrderCtrl.translations['antibody.pdp.commerceCard.promotion.promocode']}}: {{promo.promoCode}} {{promo.promoTitle}} {{promo.promoDescription}}. {{$productOrderCtrl.translations['antibody.pdp.commerceCard.promotion.learnmore']}}
产品信息
PA5-56569
种属反应
宿主/亚型
分类
类型
抗原
偶联物
形式
浓度
规格
纯化类型
保存液
内含物
保存条件
运输条件
RRID
产品详细信息
Immunogen sequence: EQHINIDTLT SDPRLYMKIS GNAMLQLG
Highest antigen sequence identity to the following orthologs: Mouse - 93%, Rat - 89%.
靶标信息
The ATP11C gene encodes a protein that belongs to the P4-ATPase family, specifically functioning as a phospholipid-transporting ATPase. ATP11C plays a critical role in the maintenance of phospholipid asymmetry across the cell membrane by transporting aminophospholipids from the outer leaflet to the inner leaflet of the plasma membrane. This activity is essential for various biological processes, including cell membrane integrity, cell signaling, and apoptosis. ATP11C is particularly important in hematopoiesis, influencing the development of B cells and red blood cells. Mutations or dysregulation in ATP11C can lead to disruptions in cell membrane dynamics and are associated with immunological disorders and anemia. Research on ATP11C continues to focus on its role in phospholipid transport and its implications for cellular function and disease, particularly in the context of blood-related disorders.
仅用于科研。不用于诊断过程。未经明确授权不得转售。
篇参考文献 (0)
生物信息学
蛋白别名: ATPase class VI type 11C; ATPase IQ; ATPase, class VI, type 11C; P4-ATPase flippase complex alpha subunit ATP11C; Phospholipid-transporting ATPase IG; probable phospholipid-transporting ATPase IG; unnamed protein product
基因别名: ATP11C; ATPIG; ATPIQ; HACXL
UniProt ID: (Human) Q8NB49
Entrez Gene ID: (Human) 286410